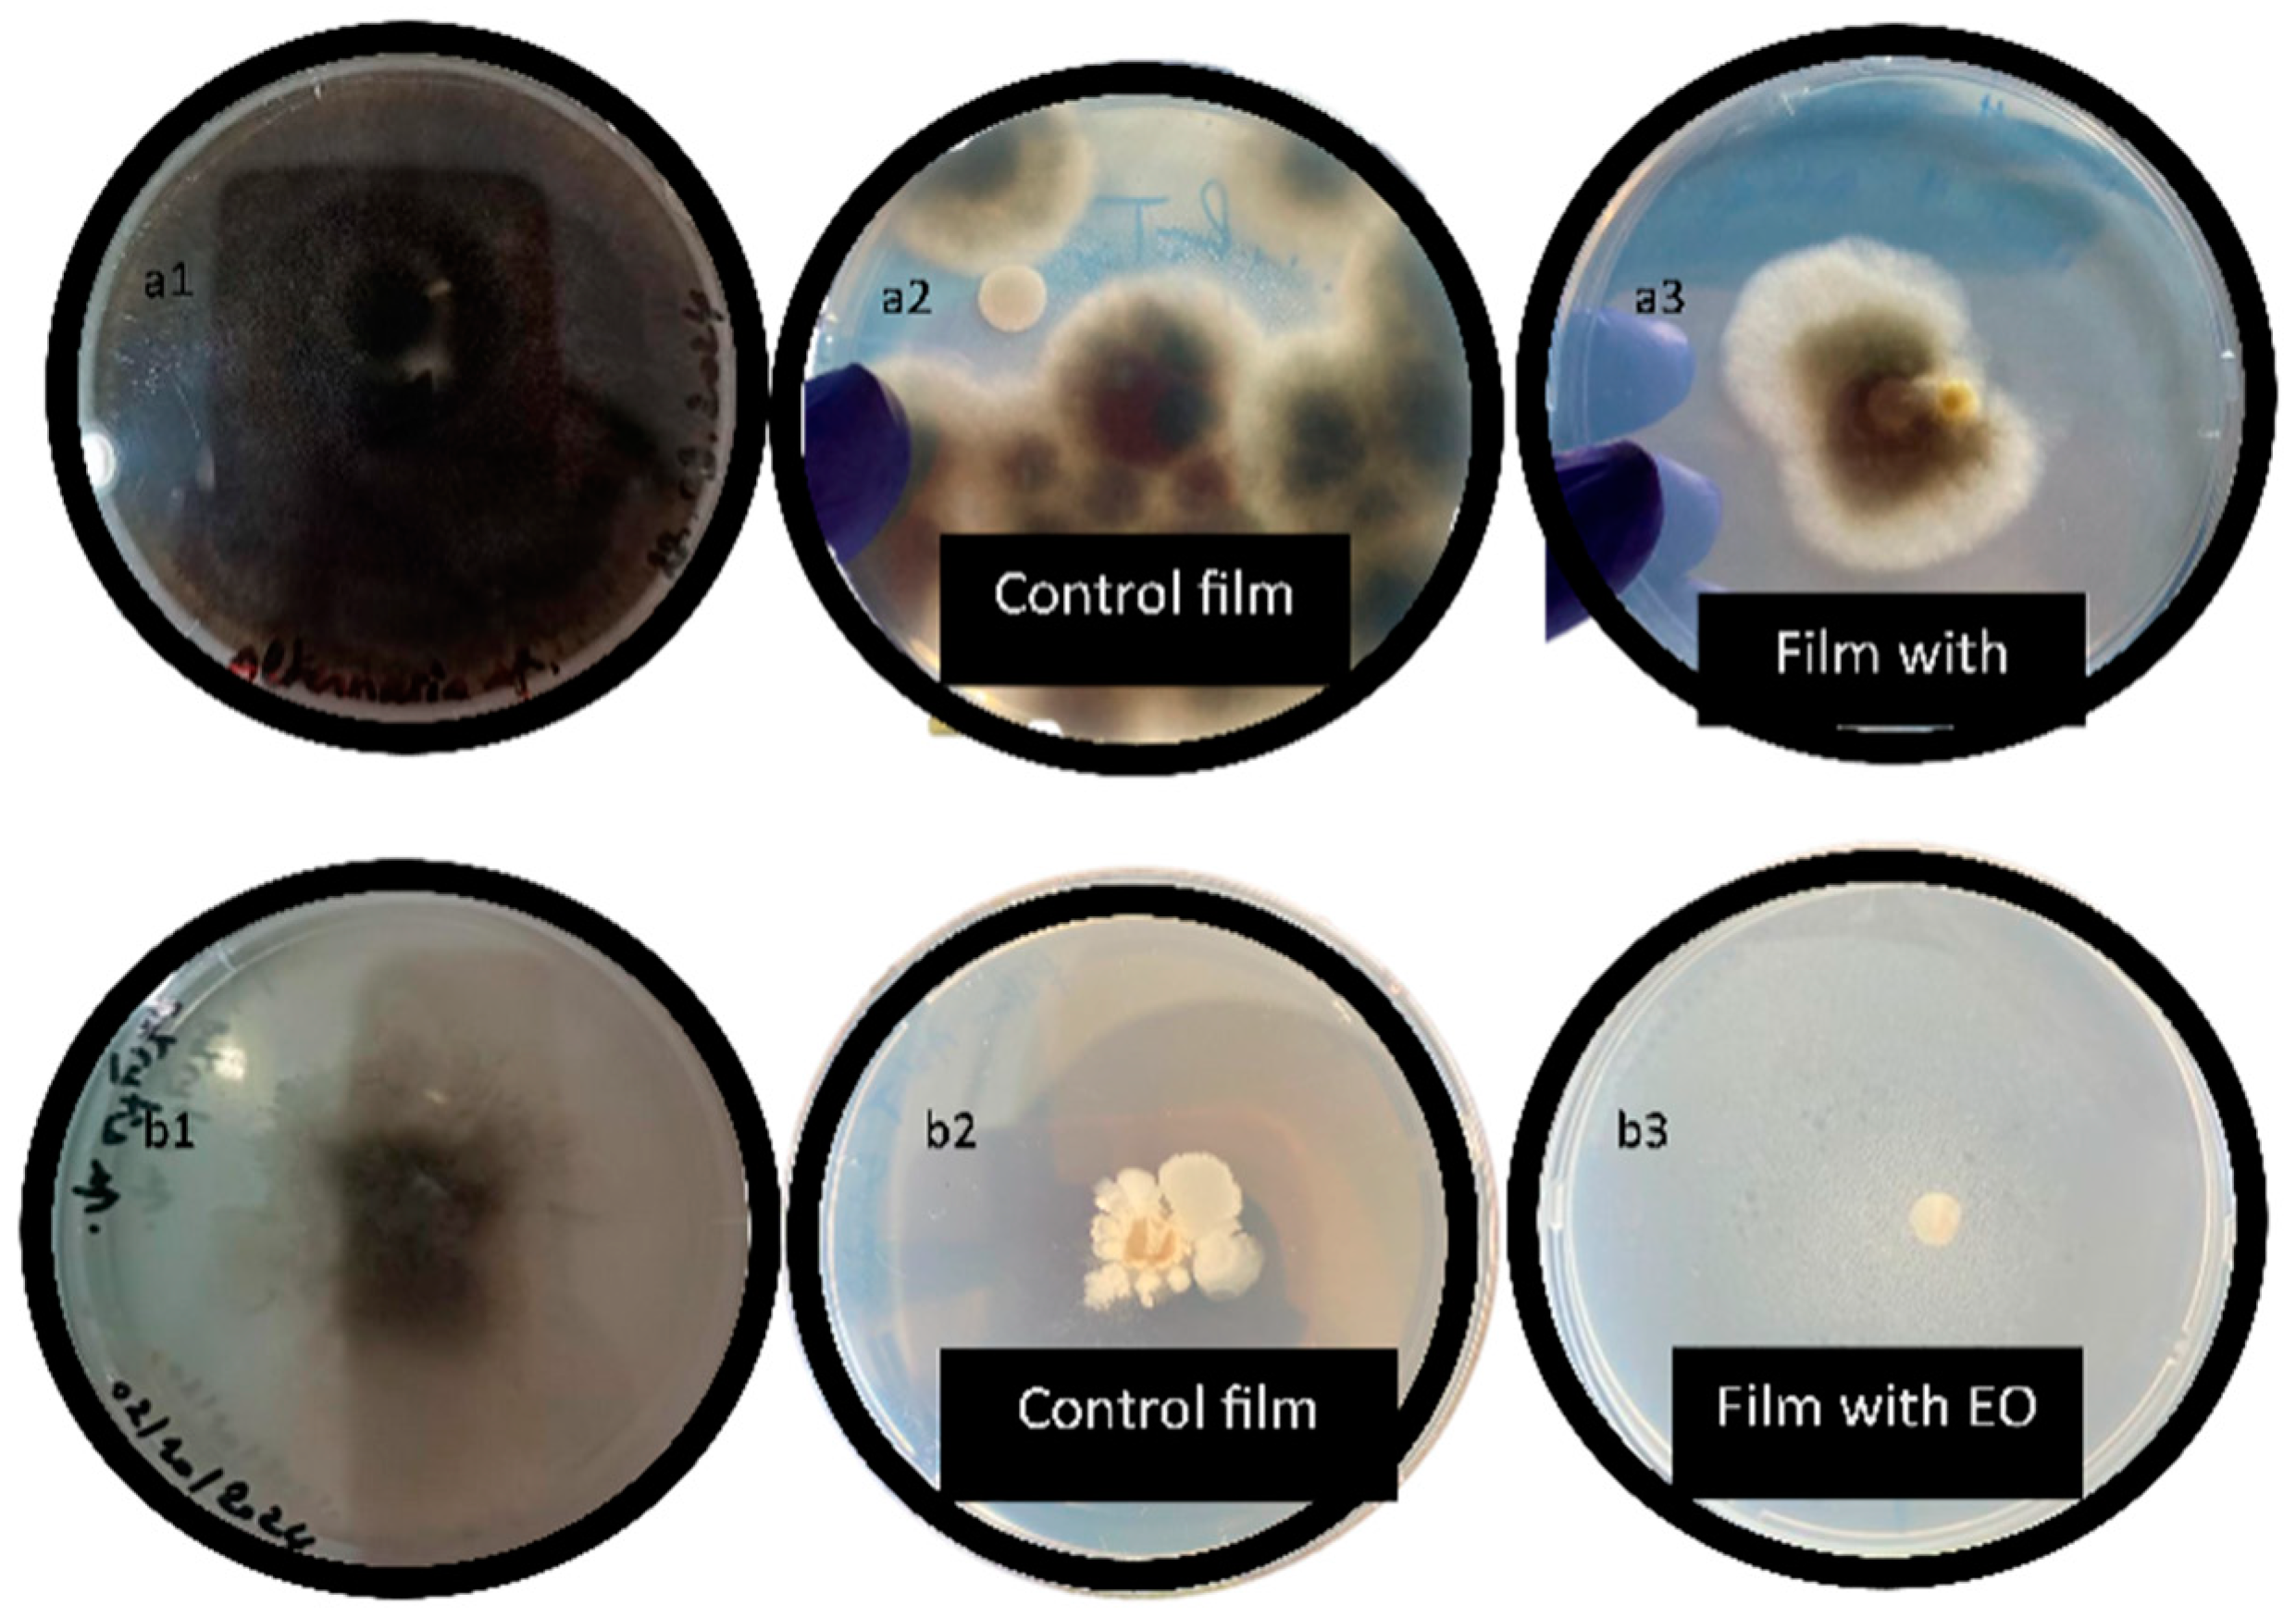

Development of Pectin-Based Films with Encapsulated Lemon Essential Oil for Active Food Packaging: Improved Antioxidant Activity and Biodegradation
Abstract
1. Introduction
2. Materials and Methods
2.1. Materials
2.2. Extraction of Essential Oil
2.3. Pectin Extraction
2.4. Encapsulation of the Bioactive Compounds in Pectin
2.5. Preparation of Pectin-Based Biodegradable Films
2.6. Properties of Pectin Film
2.6.1. Film Thickness Measurement
2.6.2. Moisture Content
2.6.3. Water Solubility and Swelling Rate
2.6.4. Film Opacity
2.6.5. Biodegradability Test
2.6.6. Measurement of Antioxidant Activity by DPPH
2.6.7. Fourier-Transform Infrared (FTIR) Analysis
2.6.8. Film Morphology
2.6.9. Mechanical Properties
2.7. Antibacterial Activity
2.8. Antifungal Activity
- I: Inhibition rate (%).
- C: Radial growth of the fungal colony in the control group (DMSO only).
- T: Radial growth of the fungal colony in the presence of the tested film sample.
2.9. Application for Preserving Fresh-Cut Apples
2.9.1. Sample Preparation
2.9.2. Physico-Chemical Traits
2.10. Data Analysis
3. Results and Discussion
3.1. Properties of Pectin Film
3.1.1. Film Thickness Measurement
3.1.2. Moisture Content
3.1.3. Water Solubility and Swelling Rate
3.1.4. Film Transparency
3.1.5. Biodegradability Test
3.1.6. Test of DPPH
3.1.7. FTIR Analysis
3.1.8. Film Morphology
3.1.9. Mechanical Properties
3.2. Antibacterial Activity
3.3. Antifungal Activity
3.4. Effect of Pectin–EO-Based Film on Physico-Chemical Features
4. Conclusions
Author Contributions
Funding
Institutional Review Board Statement
Informed Consent Statement
Data Availability Statement
Acknowledgments
Conflicts of Interest
References
- Realini, C.E.; Marcos, B. Active and intelligent packaging systems for a modern society. Meat Sci. 2014, 98, 404–419. [Google Scholar] [CrossRef] [PubMed]
- Qian, M.; Liu, D.; Zhang, X.; Yin, Z.; Ismail, B.B.; Ye, X.; Guo, M. A review of active packaging in bakery products: Applications and future trends. Trends Food Sci. Technol. 2021, 114, 459–471. [Google Scholar] [CrossRef]
- Alizadeh-Sani, M.; Mohammadian, E.; Rhim, J.W.; Jafari, S.M. pH-sensitive (halochromic) smart packaging films based on natural food colorants for the monitoring of food quality and safety. Trends Food Sci. Technol. 2020, 105, 93–144. [Google Scholar] [CrossRef]
- Sani, M.A.; Azizi-Lalabadi, M.; Tavassoli, M.; Mohammadi, K.; McClements, D.J. Recent advances in the development of smart and active biodegradable packaging materials. Nanomaterials 2021, 11, 1331. [Google Scholar] [CrossRef] [PubMed]
- Adilah, A.N.; Jamilah, B.; Noranizan, M.A.; Hanani, Z.N. Utilization of Mango Peel Extracts on the Biodegradable Films for Active Packaging. Food Packag. Shelf Life 2018, 16, 1–7. [Google Scholar] [CrossRef]
- Ledesma-Escobar, C.A.; de Castro, M.D.L. Towards a comprehensive exploitation of citrus. Trends Food Sci. Technol. 2014, 39, 63–75. [Google Scholar] [CrossRef]
- Santiago, B.; Moreira, M.T.; Feijoo, G.; Gonzalez-Garcia, S. Identification of environmental aspects of citrus waste valorization into D-limonene from a biorefinery approach. Biomass Bioenergy 2020, 143, 105844. [Google Scholar] [CrossRef]
- FAO STAT. Food and Agriculture Data; Food and Agriculture Organization (FAO): Rome, Italy, 2019; Available online: http://www.fao.org/faostat/en/?#data/QC (accessed on 19 September 2024).
- Suri, S.; Singh, A.; Nema, P.K. Recent advances in valorization of citrus fruits processing waste: A way forward towards environmental sustainability. Food Sci. Biotechnol. 2021, 30, 1601–1626. [Google Scholar] [CrossRef] [PubMed]
- Bouziane, H. Contribution à l’Elaboration de Nouveaux Systèmes de Libération des Médicaments à Base de Composites Pectine-Chitosane. Master’s Thesis, Yahia Fares University of Medea, Medea, Algeria, 2016. [Google Scholar]
- Dirpan, A.; Deliana, Y.; Ainani, A.F.; Bahmid, N.A. Exploring the Potential of Pectin as a Source of Biopolymers for Active and Intelligent Packaging: A Review. Polymers 2024, 16, 2783. [Google Scholar] [CrossRef]
- Bharadvaja, N. Aromatic plants: A multifaceted asset. Braz. J. Bot. 2023, 46, 241–254. [Google Scholar]
- Yahyaoui, M. Application des Huiles Essentielles Dans le Domaine des Embalages Alimentaires. Ph.D. Thesis, Universidad del País Vasco-Euskal Herriko Unibertsitatea, Leioa, Spain, 2020. [Google Scholar]
- M’Hiri, N. Étude Comparative de l’Effet des Méthodes d’Extraction sur les Phénols et l’Activité Antioxydante des Extraits des Ecorces «Maltaise demi Sanguine» et Exploration de l’Effet Inhibiteur de la Corrosion de l’Acier au Carbone; Université de Lorraine: Tunis, Tunisia, 2015; pp. 1–2-3-10-11. [Google Scholar]
- Herrera, P.; Aydin, M.; Park, S.H.; Khatiwara, A.; Ahn, S. Utility of egg yolk antibodies for detection and control of foodborne Salmonella. Agric. Food Anal. Bacteriol. 2013, 3, 195–217. [Google Scholar]
- Rehman, A.; Jafari, S.M.; Aadil, R.M.; Assadpour, E.; Randhawa, M.A.; Mahmood, S. Development of active food packaging via incorporation of biopolymeric nanocarriers containing essential oils. Trends Food Sci. Technol. 2020, 101, 106–121. [Google Scholar] [CrossRef]
- Zabot, G.L.; Rodrigues, F.S.; Ody, L.P.; Vin, M.; Herrera, E.; Palacin, H.; Javier, S.C.; Best, I.; Olivera-montenegro, L. Encapsulation of Bioactive Compounds for Food and Agricultural Applications. Polymers 2022, 14, 4194. [Google Scholar] [CrossRef]
- Council of Europe. European Pharmacopoeia 10.0; Council of Europe: Strasbourg, France, 2019. [Google Scholar]
- Jamdar, F.; Ali Mortazavi, S.; Reza Saiedi Asl, M.; Sharifi, A. Physicochemical properties and enzymatic activity of wheat germ extract microencapsulated with spray and freeze drying. Food Sci. Nutr. 2021, 9, 1192–1201. [Google Scholar] [CrossRef] [PubMed]
- Wang, Q.; Tian, F.; Feng, Z.; Fan, X.; Pan, Z.; Zhou, J. Antioxidant activity and physicochemical properties of chitosan films incorporated with Lyciumbarbarum fruit extract for active food packaging. Int. J. Food Sci. Technol. 2015, 50, 458–464. [Google Scholar] [CrossRef]
- Ahmed, S.; Ikram, S. Chitosan and Gelatin Based Biodegradable Packaging Films with UV-Light Protection. J. Photochem. Photobiol. B Biol. 2016, 163, 115–124. [Google Scholar] [CrossRef] [PubMed]
- Zareen, S.; Nawab, A.; Alam, F.; Hadi, A. The impact of heat-moisture treatment and pre-gelatinization on functional, mechanical, and barrier properties of basmati rice starch films. Cereal Chem. 2023, 100, 675–684. [Google Scholar] [CrossRef]
- Wu, C.S. Preparation, characterization, and biodegradability of renewable resource-based composites from recycled polylactide bioplastic and sisal fibers. J. Appl. Polym. Sci. 2012, 123, 347–355. [Google Scholar] [CrossRef]
- Cui, Y.; Cheng, Y.; Xu, Z.; Li, B.; Tian, W.; Zhang, J. Cellulose-Based Transparent Edible Antibacterial Oxygen-Barrier Coating for Long-Term Fruit Preservation. Adv. Sci. 2024, 2409560. [Google Scholar] [CrossRef] [PubMed]
- Chen, C.W.; Xie, J.; Yang, F.X.; Zhang, H.L.; Xu, Z.W.; Liu, J.L.; Chen, Y.J. Development of Moisture-Absorbing and Antioxidant Active Packaging Film Based on Poly (Vinyl Alcohol) Incorporated with Green Tea Extract and Its Effect on the Quality of Dried Eel. J. Food Process. Preserv. 2018, 42, e13374. [Google Scholar] [CrossRef]
- Moore, G.R.P.; Martelli, S.M.; Gandolfo, C.; do Amaral Sobral, P.J.; Laurindo, J.B. Influence of the glycerol concentration on some physical properties of feather keratin films. Food Hydrocoll. 2006, 20, 975–982. [Google Scholar] [CrossRef]
- ASTM D882. Available online: https://www.instron.com/en/testing-solutions/astm-standards/astm-d882 (accessed on 5 November 2024).
- Shemesh, R.; Krepker, M.; Goldman, D.; Danin-Poleg, Y.; Kashi, Y.; Nitzan, N.; Vaxman, A.; Segal, E. Antibacterial and antifungal LDPE films for active packaging. Polym. Adv. Technol. 2015, 26, 110–116. [Google Scholar] [CrossRef]
- De Carvalho, G.R.; Kudaka, A.M.; Netto, R.A.; Delarmelina, C.; Duarte, M.C.T.; Lona, L.M.F. Antiviral and antibacterial activity of sodium alginate/poly (diallyldimethylammonium chloride) polyelectrolyte film for packaging applications. Int. J. Biol. Macromol. 2023, 244, 125388. [Google Scholar] [CrossRef]
- Jiang, H.; Zhang, W.; Khan, M.R.; Ahmad, N.; Rhim, J.W.; Jiang, W.; Roy, S. Film Properties of Pectin Obtained from Various Fruits’ (Lemon Pomelo Pitaya) Peels. J. Compos. Sci. 2023, 7, 366. [Google Scholar] [CrossRef]
- Li, Y.; Guo, L.; Yi, X.; Xu, Q.; Zhang, Q.; Zhou, Y.; Li, X.; Chen, B.; Zhao, N.; Pan, W.; et al. Fabrication and characterization of Plumula nelumbinis extract loaded gelatin/zein films (PNE@ GZF) to prolong strawberries shelf-life. Food Control 2023, 154, 109989. [Google Scholar] [CrossRef]
- Wu, J.; Chen, S.; Ge, S.; Miao, J.; Li, J.; Zhang, Q. Preparation, properties and antioxidant activity of an active film from silver carp (Hypophthalmichthys molitrix) skin gelatin incorporated with green tea extract. Food Hydrocoll. 2013, 32, 42–51. [Google Scholar] [CrossRef]
- Furlan, G.R.; Silvestre, W.P.; Baldasso, C. Pectin-based films with thyme essential oil: Production, characterization, antimicrobial activity, and biodegradability. Polímeros 2023, 33, e20230029. [Google Scholar] [CrossRef]
- Wang, L.; Dong, Y.; Men, H.; Tong, J.; Zhou, J. Preparation and characterization of active films based on chitosan incorporated tea polyphenols. Food Hydrocoll. 2013, 32, 35–41. [Google Scholar] [CrossRef]
- Venkatachalam, K.; Charoenphun, N.; Noonim, P.; Pechwang, J.; Lekjing, S. Influence of pomelo pericarp essential oil on the structural characteristics of gelatin-arrowroot tuber flour-based edible films. RSC Adv. 2024, 14, 27274–27287. [Google Scholar] [CrossRef] [PubMed]
- Kurtfaki, M.; Yildirim-Yalcin, M. Characterization of Laurus nobilis L. leaf essential oil incorporated maize starch and rice protein films. J. Food Meas. Charact. 2023, 17, 4954–4962. [Google Scholar] [CrossRef]
- Norajit, K.; Kim, K.M.; Ryu, G.H. Comparative studies on the characterization and antioxidant properties of biodegradable alginate films containing ginseng extract. J. Food Eng. 2010, 98, 377–384. [Google Scholar] [CrossRef]
- He, X.; Li, M.; Gong, X.; Niu, B.; Li, W. Biodegradable and antimicrobial CSC films containing cinnamon essential oil for preservation applications. Food Packag. Shelf Life 2021, 29, 100697. [Google Scholar] [CrossRef]
- Kumar, H.; Ahuja, A.; Kadam, A.A.; Rastogi, V.K.; Negi, Y.S. Antioxidant film based on chitosan and tulsi essential oil for food packaging. Food Bioprocess Technol. 2023, 16, 342–355. [Google Scholar] [CrossRef]
- Nisar, M.F.; Anwar, M.; Khan, M.I. Characteristics and antimicrobial properties of active edible films based on pectin and nanochitosan. J. Food Sci. 2023, 88, 1024–1035. [Google Scholar]
- Han, H.S.; Song, K.B. Antioxidant activities of mandarin (Citrus unshiu) peel pectin films containing sage (Salvia officinalis) leaf extract. Int. J. Biol. Macromol. 2020, 55, 3173–3181. [Google Scholar] [CrossRef]
- Baghi, F.; Ghnimi, S.; Dumas, E.; Chihib, N.E.; Gharsallaoui, A. Nanoemulsion-based multilayer films for ground beef preservation: Antimicrobial activity and physicochemical properties. Molecules 2023, 28, 4274. [Google Scholar] [CrossRef]
- Vahedikia, N.; Garavand, F.; Tajeddin, B.; Cacciotti, I.; Jafari, S.M.; Omidi, T.; Zahedi, Z. Biodegradable zein film composites reinforced with chitosan nanoparticles and cinnamon essential oil: Physical mechanical structural and antimicrobial attributes. Colloids Surf. B Biointerfaces 2019, 177, 25–32. [Google Scholar] [CrossRef]
- Calo, J.R.; Crandall, P.G.; O’Bryan, C.A.; Ricke, S.C. Essential oils as antimicrobials in food systems—A review. Food Control 2015, 54, 111–119. [Google Scholar] [CrossRef]
- Bhavaniramya, S.; Vishnupriya, S.; Al-Aboody, M.S.; Vijayakumar, R.; Baskaran, D. Role of essential oils in food safety: Antimicrobial and antioxidant applications. Grain Oil Sci. Technol. 2019, 2, 49–55. [Google Scholar] [CrossRef]
- Bharti, S.K.; Pathak, V.; Alam, T.; Arya, A.; Singh, V.K.; Verma, A.K.; Rajkumar, V. Starch bio-based composite active edible film functionalized with Carum carvi L. essential oil: Antimicrobial, rheological, physic-mechanical and optical attributes. J. Food Sci. Technol. 2022, 59, 456–466. [Google Scholar]
- Alvarez, M.V.; Palou, L.; Taberner, V.; Fernández-Catalán, A.; Argente-Sanchis, M.; Pitta, E.; Pérez-Gago, M.B. Natural pectin-based edible composite coatings with antifungal properties to control green mold and reduce losses of ‘Valencia’ oranges. Foods 2022, 11, 1083. [Google Scholar] [CrossRef] [PubMed]

| Characteristics of Strain Growth | Effect |
|---|---|
| Growth inhibition zone > 1 mm around the film and under the film | +++ Very good activity |
| Growth inhibition zone < 1 mm around the film or only under the film | ++ Good activity |
| No inhibition zone around the film and slight inhibition under the film | + Low activity |
| No growth inhibition around or under the film | − Lack of activity |
| Film Samples | Thickness (mm) | Moisture Content% | Water Solubility% | Swelling Rate | Film Opacity |
|---|---|---|---|---|---|
| Control | 0.089 ± 0.001 | 35.236 | 15.315 | 0.228 ± 0.040 | 0.290 ± 0.012 |
| Film with EO | 0.097 ± 0.008 | 28.894 | 16.046 | 0.189 ± 0.003 | 0.350 ± 0.020 |
| Film with EO | Film without EO |
|---|---|
| 63.60% ± 0.001 | 21.37% ± 0.001 |
| Film Sample | Elongation (%) | Strength (MPa) | Young’s Modulus (MPa) |
|---|---|---|---|
| Control Film | 11.52 ± 0.123 | 12.28 ± 1.271 | 494.77 ± 0.519 |
| Film with EO | 20.05 ± 0.784 | 14.68 ± 1.419 | 174.73 ± 1.915 |
| Film | Control Film | Film with EO |
|---|---|---|
| Staphylococcus aureus (mm) | - | 0.930 ± 0.574 (++) |
| - | - | |
| Escherichia coli (mm) | - | - |
| - | - | |
| Bacillus cereus (mm) | - | 0.750 ± 0.203 (++) |
| Pseudomonas aeruginosa (mm) | - | - |
| - | - |
| Film | Control Film | Film with EO |
|---|---|---|
| Inhibition (%) Botrytis cinerea | 70 ± 2.500 | 100 ± 0.000 |
| Inhibition (%) Alternaria alternata | 10 ± 4.800 | 50 ± 1.700 |
Disclaimer/Publisher’s Note: The statements, opinions and data contained in all publications are solely those of the individual author(s) and contributor(s) and not of MDPI and/or the editor(s). MDPI and/or the editor(s) disclaim responsibility for any injury to people or property resulting from any ideas, methods, instructions or products referred to in the content. |
© 2025 by the authors. Licensee MDPI, Basel, Switzerland. This article is an open access article distributed under the terms and conditions of the Creative Commons Attribution (CC BY) license (https://creativecommons.org/licenses/by/4.0/).
Share and Cite
Akachat, B.; Himed, L.; Salah, M.; D’Elia, M.; Rastrelli, L.; Barkat, M. Development of Pectin-Based Films with Encapsulated Lemon Essential Oil for Active Food Packaging: Improved Antioxidant Activity and Biodegradation. Foods 2025, 14, 353. https://doi.org/10.3390/foods14030353
Akachat B, Himed L, Salah M, D’Elia M, Rastrelli L, Barkat M. Development of Pectin-Based Films with Encapsulated Lemon Essential Oil for Active Food Packaging: Improved Antioxidant Activity and Biodegradation. Foods. 2025; 14(3):353. https://doi.org/10.3390/foods14030353
Chicago/Turabian StyleAkachat, Belkis, Louiza Himed, Merniz Salah, Maria D’Elia, Luca Rastrelli, and Malika Barkat. 2025. "Development of Pectin-Based Films with Encapsulated Lemon Essential Oil for Active Food Packaging: Improved Antioxidant Activity and Biodegradation" Foods 14, no. 3: 353. https://doi.org/10.3390/foods14030353
APA StyleAkachat, B., Himed, L., Salah, M., D’Elia, M., Rastrelli, L., & Barkat, M. (2025). Development of Pectin-Based Films with Encapsulated Lemon Essential Oil for Active Food Packaging: Improved Antioxidant Activity and Biodegradation. Foods, 14(3), 353. https://doi.org/10.3390/foods14030353

